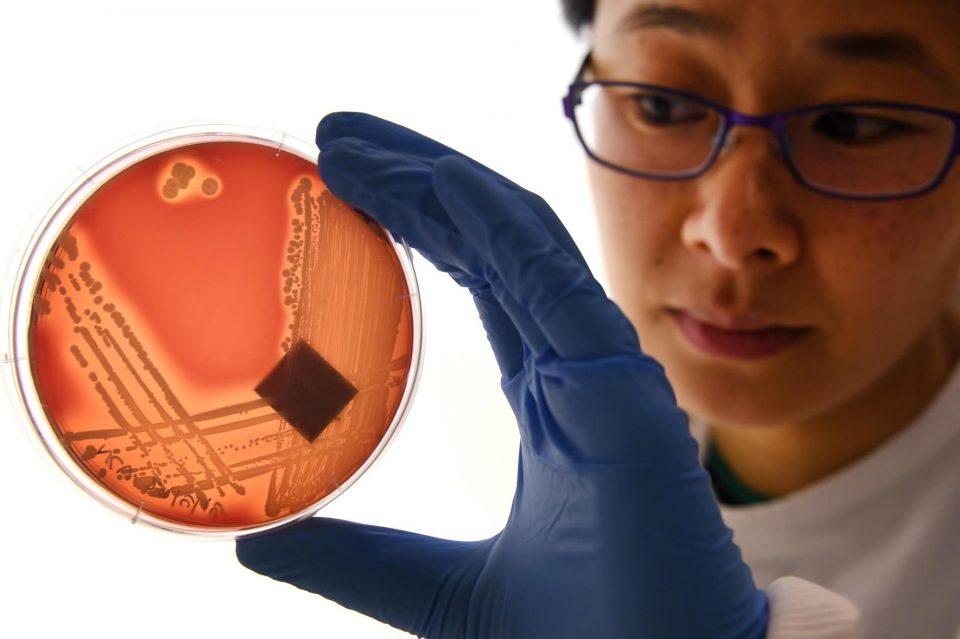

Whilst public education means we’re all probably getting better at realising that antibiotics should be used sparingly, official warnings continue nevertheless that antibiotic resistance has become one of the biggest threats to our health globally.
The World Health Organisation (WHO) makes no bones about it: “Antibiotic resistance is rising to dangerously high levels in all parts of the world… Without urgent action, we are heading for a post-antibiotic era, in which common infections and minor injuries can once again kill.”
To put this in context, a future without effective antibiotics would mean that commonplace medical surgeries, such as hip replacements, cancer chemotherapy, organ transplants and the treatment of pre-term babies, would be far less safe. It’s a terrifying thought.
Predictions suggest that if we don’t radically change how antibiotics are used, antimicrobial resistance will kill more people by mid-century than cancer does today.
A recent report from Antibiotic Research UK found a 17 per cent decrease in antibiotic prescriptions during the first year of the pandemic in England, “hinting at the scale of over-prescription during normal times”. Whilst it could have been due to many factors, including less infection transmission during lockdowns and fewer visits to the GP, it is encouraging that there are clear ways to reduce antibiotic use in people.
Hidden threat
However, reducing the overuse of antibiotics for people is less than half the story, because the greater share of these vital drugs is used in animal farming.
Worldwide, about two-thirds of all antibiotics are used in farm animals, not people. Much of this use is routine and enables the keeping of farmed animals in cruel, cramped and stressful conditions where diseases spread easily.
Leading authorities such as the European Medicines Agency and the WHO say that the overuse of antibiotics in farming contributes to higher levels of antibiotic resistance in some human infections.
In the UK, British livestock farmers have made good progress in reducing their antibiotic use, which now account for about 26 per cent of all British antibiotic use. British pig and poultry farmers have reduced or, in some cases, ended routine use. This progress is welcome, however, much more needs to be done.
Consumers choice
As well as calling for action in farming and human medicine, I always like to provide a message for consumers on how to make the world a better place through food choices.
However, a new report throws doubt on how confident we can be about buying foods produced without overuse of antibiotics from supermarkets.
A new report by the Alliance to Save our Antibiotics found that meat, dairy and eggs produced with the misuse of antibiotics could still be making its way onto UK supermarket shelves, due to inadequate policies.
Despite some improvements, the report finds that most imports and branded products are not covered by the supermarkets’ own rules for responsible antibiotic use.
This means that there is no reliable way for shoppers to avoid buying food produced with irresponsible antibiotic use.
Trade concerns
This is particularly concerning because the government is in trade talks with countries, like the US and Australia, where antibiotics are still used for growth promotion, a practice banned in the UK. The ban on growth promoters does not apply to imported food, a loophole which neither the government nor most of the supermarkets have addressed.
To my mind, supermarkets have a responsibility to ensure that all meat, dairy and eggs they sell is produced without misusing antibiotics and comes from farms where the animals have been kept healthy naturally.
Action needs to be taken, and quickly, to address the tangle of rules that mean consumers just cannot tell whether the food they are buying has been responsibly farmed or not. And things could get worse if trade deals don’t prevent the import of products farmed in ways – like using antibiotics as growth promoters – that have long been banned in this country.
It’s good to see TV’s Dr Chris Van Tulleken, an infectious diseases doctor and clinical research fellow at University College London Hospital, speaking out on this issue. “We need to get antibiotic misuse out of the food chain as it is contributing to the global crisis of antibiotic resistance. If we no longer have reliable, effective antibiotics, we will see a lot more deaths due to infection. This will even affect young people, including children,” he said.
Dr Tulleken is backing a petition by the Alliance to Save Our Antibiotics urging supermarkets to apply their rules for responsible antibiotic use to all animal products sold in their stores.
Animal and human health are intertwined
In the end, government and supermarket policies are only going to be truly effective if every animal, in every supply chain, is protected. It is long past time for rhetoric. As with the threat of climate change, the stakes are simply too high, we need action.
Transformation of our food systems is essential if we are not to lose essentials that we currently take for granted, antibiotics being a case in point.
It is but another reminder that the well-being of people is closely linked to the health and welfare of animals and the environment. If we kept farmed animals in decent conditions, it would drastically reduce the amount of routine antibiotics needed to ward off diseases inherent in questionable husbandry practices.
Ultimately, protecting people means protecting animals too.
Philip Lymbery is global chief executive of Compassion in World Farming International and a United Nations Food Systems Champion. He is on Twitter @philip_ciwf